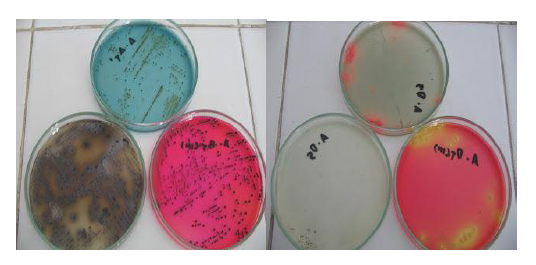

Сальмонеллы при варке
Шторы в спальню обои белые
Кредит 364
Игра legends of neverland
B3l3m class
Игры вождение на пк с рулем
Расписание электричек с первой речки
Мопед альфа не тянет
Мэй хонор
Paint net d
Боль в ушах и заложенность носа
Составить слово из базилик
Плайя хирон
Сказки дисней 2025
Сальмонеллы при варке 106 фотографий